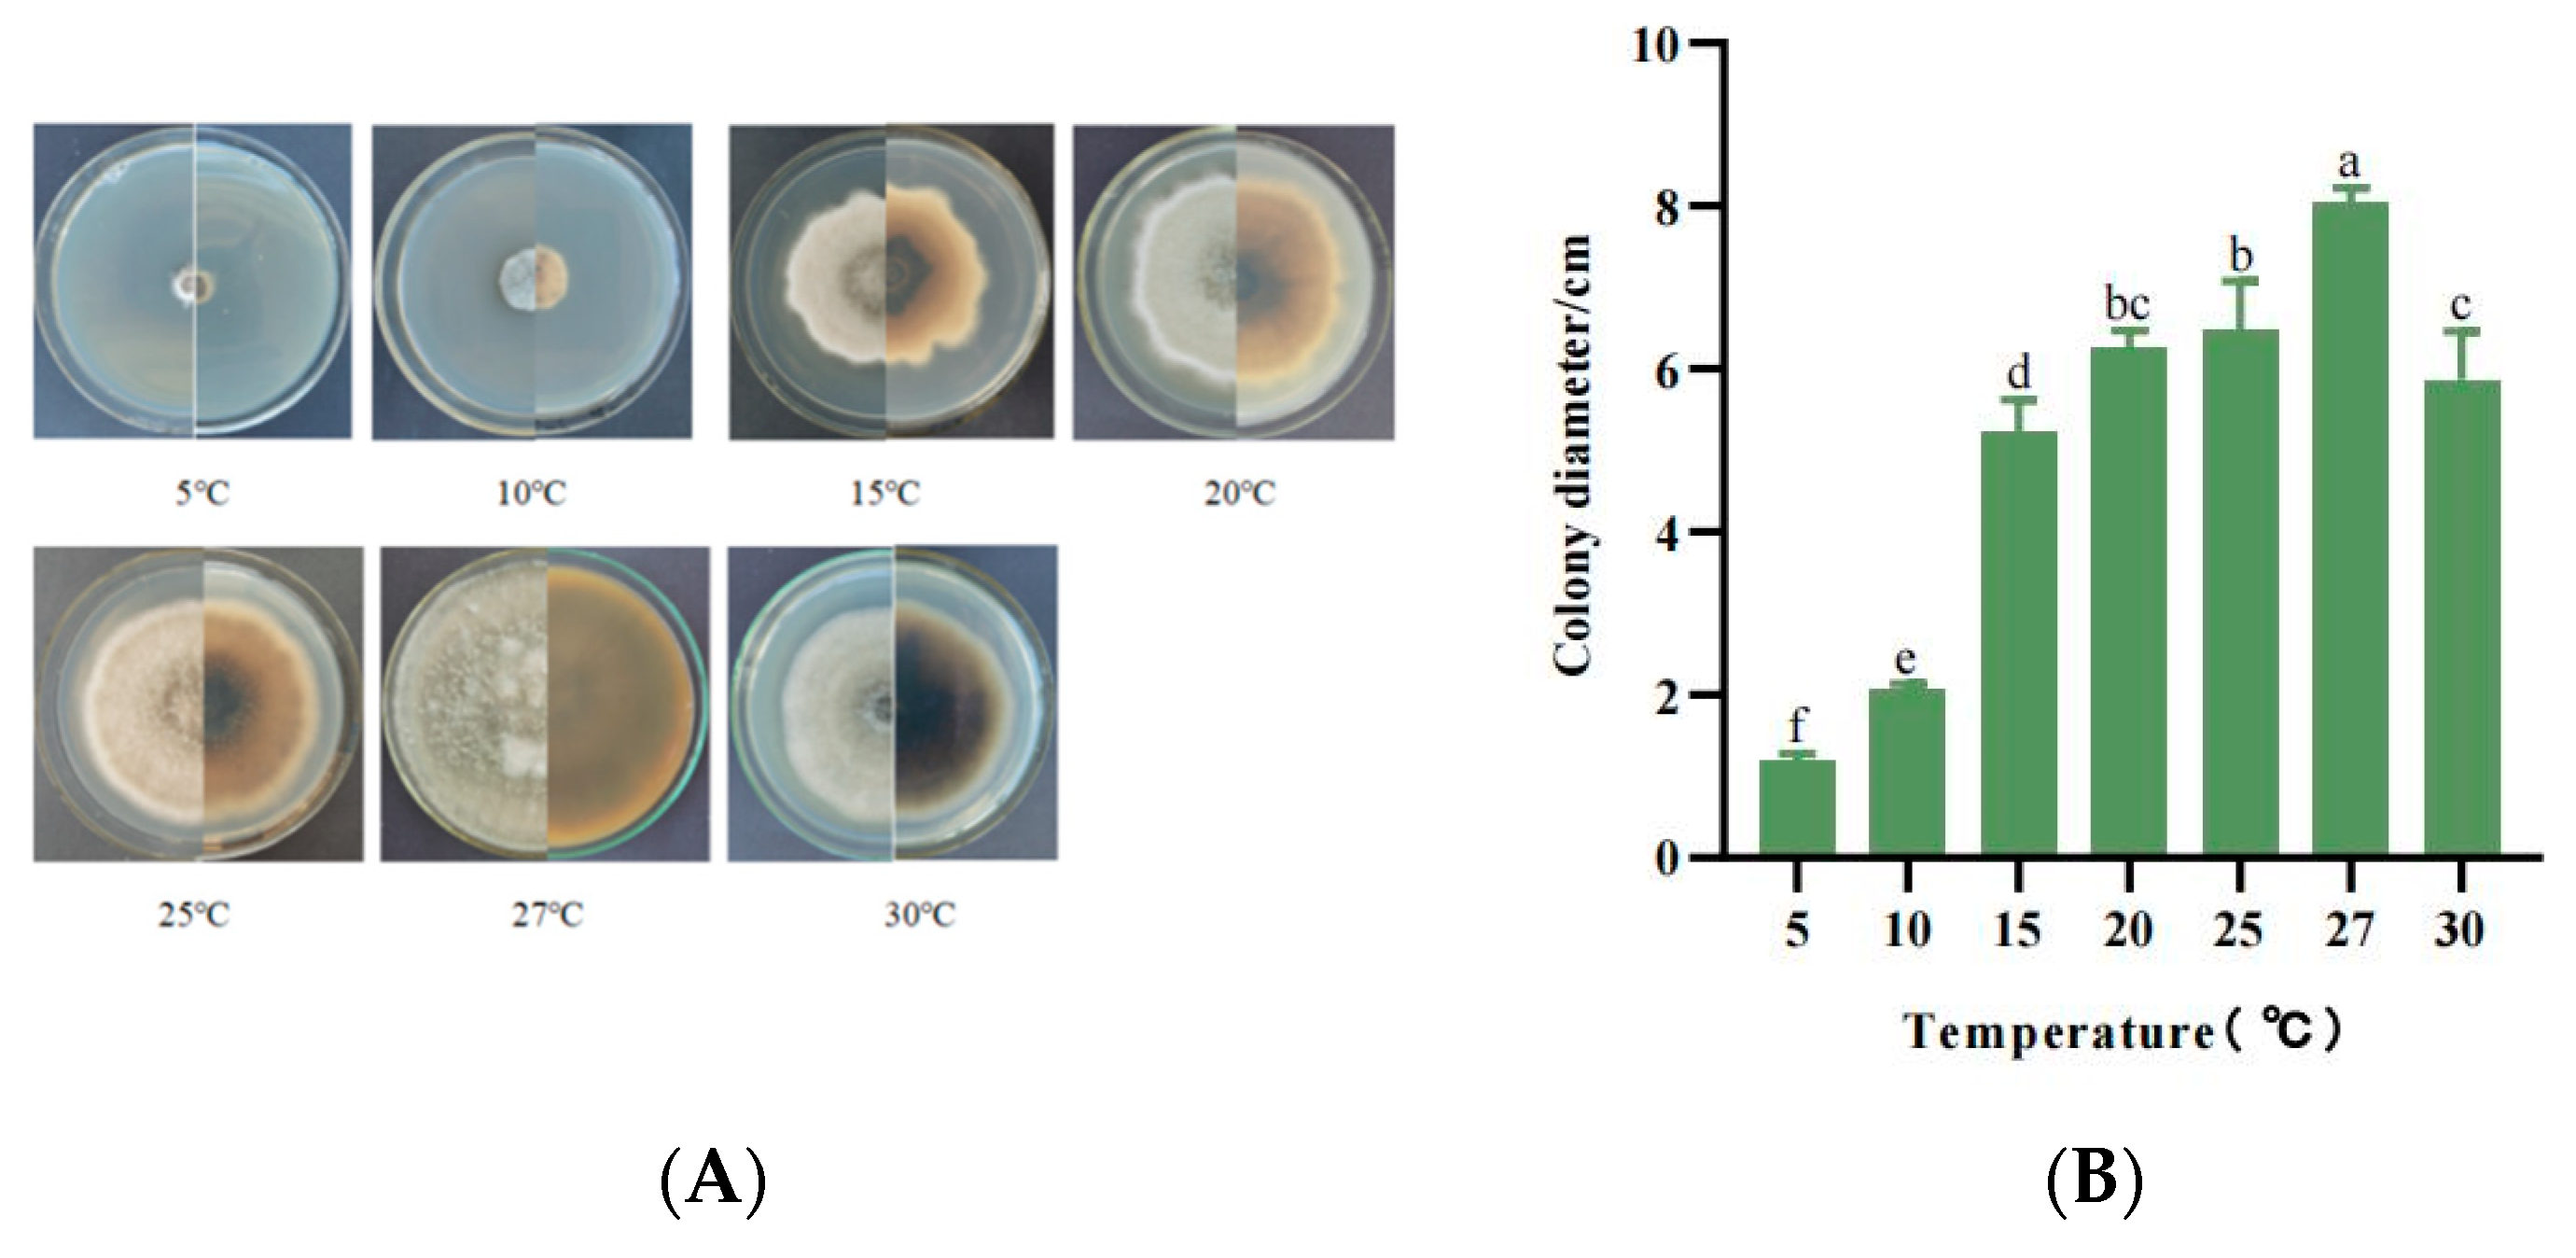
Jof 10 00691 g006 Jof 10 00691 g006
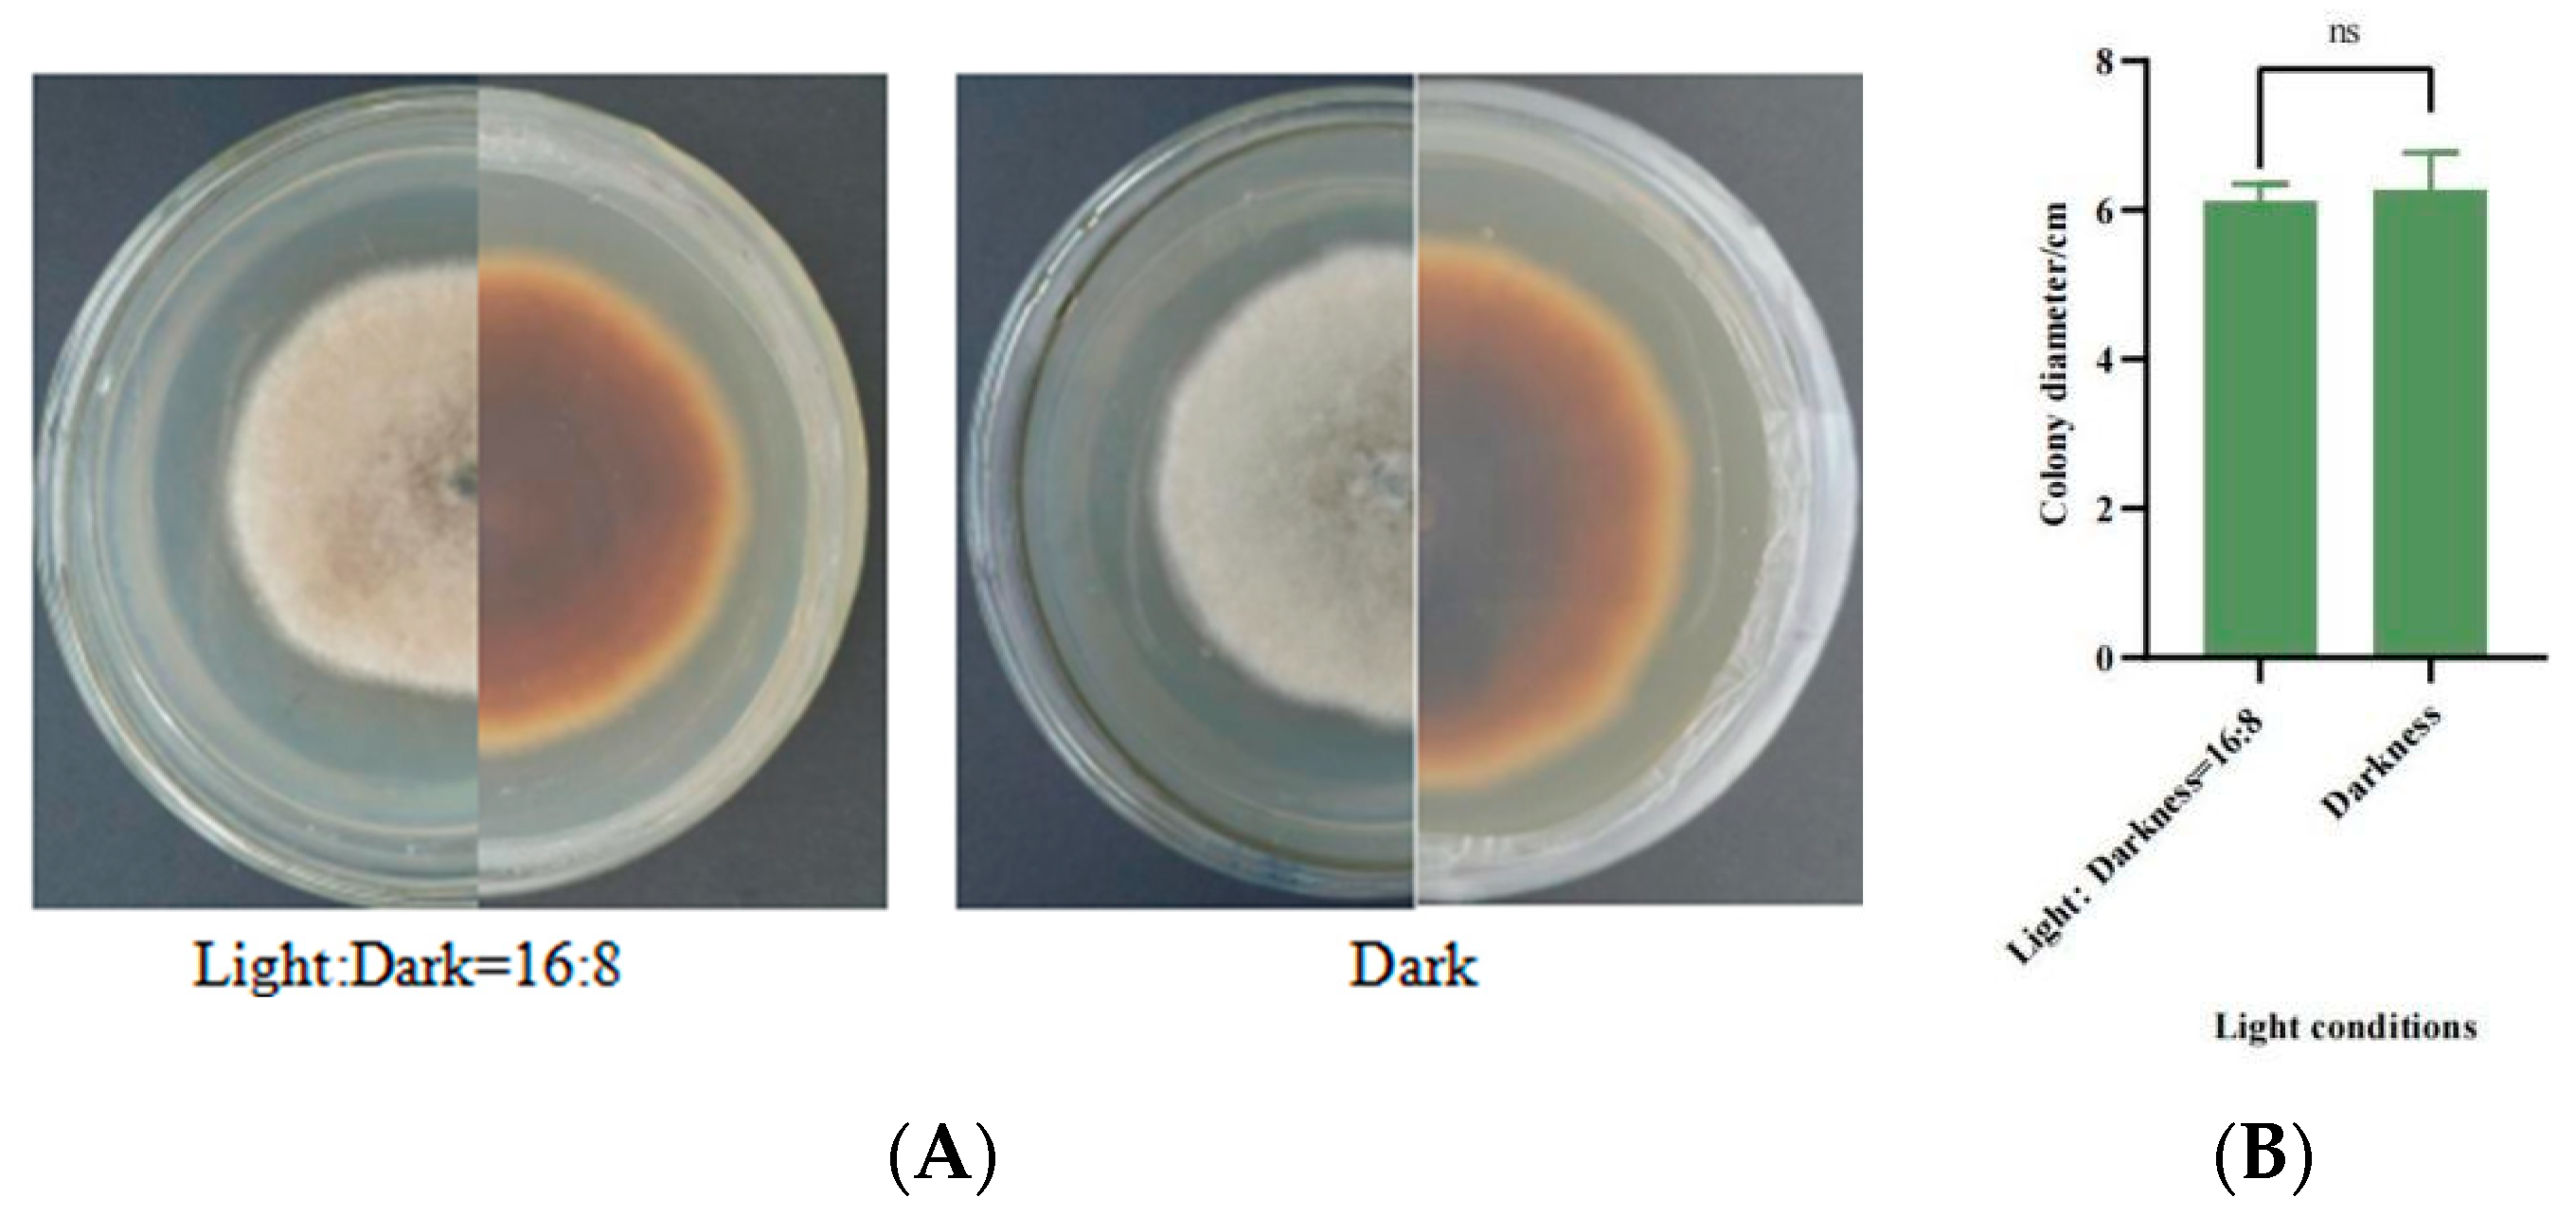
Jof 10 00691 g009 Jof 10 00691 g009

Identification and Biological Characteristics of Alternaria gossypina as a Promising Biocontrol Agent for the Control of Mikania micrantha
Abstract
1. Introduction
2. Materials and Methods
2.1. Isolation and Purification of Pathogens
2.2. Pathogenicity Tests on Host Leaves
2.3. Disease Severity Assessments
2.4. Morphological Identification of the Pathogen
2.5. Molecular Identification of Fungal Isolates
2.6. Biological Characterisation Studies
2.6.1. Effect of Different Media on Mycelial Growth
2.6.2. Effect of Different pH Values on Mycelial Growth
2.6.3. Effect of Different Temperature on Mycelial Growth
2.6.4. Mycelial Growth Characteristics with Different Carbon and Nitrogen Sources
2.6.5. Effect of Different Light Conditions on Mycelial Growth
2.7. Observation of Leaf Infection Process of M. micrantha by Strain SWFU-MM002
2.8. Statistical Analysis
3. Results
3.1. Natural Symptoms and Pathogen Isolation
3.2. Pathogenicity Studies
3.3. Morphology of Fungal Isolates
3.4. Phylogenetic Analysis
3.5. Biological Characteristics
3.5.1. Mycelial Growth Characteristics with Different Media
3.5.2. Mycelial Growth Characteristics at Different pH Values
3.5.3. Mycelial Growth Characteristics at Different Temperatures
3.5.4. Mycelial Growth Characteristics with Different Carbon Sources
3.5.5. Mycelial Growth Characteristics with Different Nitrogen Sources
3.5.6. Mycelial Growth Characteristics under Different Light Conditions
3.6. Microscopic Observation of the Infection Process of Strain SWFU-MM002 in Leaves
4. Discussion
5. Conclusions
Supplementary Materials
Author Contributions
Funding
Institutional Review Board Statement
Informed Consent Statement
Data Availability Statement
Conflicts of Interest
References
- Chen, B.-M.; Peng, S.-L.; Ni, G.-Y. Effects of the invasive plant Mikania micrantha HBK on soil nitrogen availability through allelopathy in South China. Biol. Invasions 2009, 11, 1291–1299. [Google Scholar] [CrossRef]
- Lowe, S.; Browne, M.; Boudjelas, S.; De Poorter, M. 100 of the World’s Worst Invasive Alien Species: A Selection from the Global Invasive Species Database; Invasive Species Specialist Group: Auckland, New Zealand, 2000; Volume 12. [Google Scholar]
- Zhang, L.; Ye, W.; Cao, H.; Feng, H. Mikania micrantha HBK in China—An overview. Weed Res. 2004, 44, 42–49. [Google Scholar] [CrossRef]
- Ren, X.-H. Research on Biological Control of Mikania micrantha based on Puccinia spegazzinii. Master’s Thesis, Southwest University, Chongqing, China, 2021. [Google Scholar]
- Day, M.D.; Clements, D.R.; Gile, C.; Senaratne, W.K.; Shen, S.; Weston, L.A.; Zhang, F. Biology and Impacts of Pacific Islands Invasive Species. 13. Mikania micrantha Kunth (Asteraceae) 1. Pac. Sci. 2016, 70, 257–285. [Google Scholar] [CrossRef]
- Shen, S.; Xu, G.; Zhang, F.; Jin, G.; Liu, S.; Liu, M.; Chen, A.; Zhang, Y. Harmful effects and chemical control study of Mikania micrantha HBK in Yunnan, Southwest China. Afr. J. Agric. Res. 2013, 8, 5554–5561. [Google Scholar]
- Kaur, R.; Malhotra, S.; Inderjit. Effects of invasion of Mikania micrantha on germination of rice seedlings, plant richness, chemical properties and respiration of soil. Biol. Fertil. Soils 2012, 48, 481–488. [Google Scholar] [CrossRef]
- Li, W.-H.; Zhang, C.-B.; Gao, G.-J.; Zan, Q.-J.; Yang, Z.-Y. Relationship between Mikania micrantha invasion and soil microbial biomass, respiration and functional diversity. Plant Soil 2007, 296, 197–207. [Google Scholar] [CrossRef]
- Li, W.-H.; Zhang, C.-B.; Jiang, H.-B.; Xin, G.-R.; Yang, Z.-Y. Changes in soil microbial community associated with invasion of the exotic weed, Mikania micrantha HBK. Plant Soil 2006, 281, 309–324. [Google Scholar] [CrossRef]
- Sun, F.; Ou, Q.; Yu, H.; Li, N.; Peng, C. The invasive plant Mikania micrantha affects the soil foodweb and plant-soil nutrient contents in orchards. Soil Biol. Biochem. 2019, 139, 107630. [Google Scholar] [CrossRef]
- Blackburn, T.M.; Essl, F.; Evans, T.; Hulme, P.E.; Jeschke, J.M.; Kühn, I.; Kumschick, S.; Marková, Z.; Mrugała, A.; Nentwig, W. A unified classification of alien species based on the magnitude of their environmental impacts. PLoS Biol. 2014, 12, e1001850. [Google Scholar] [CrossRef]
- Cortesero, A.; Stapel, J.; Lewis, W. Understanding and manipulating plant attributes to enhance biological control. Biol. Control 2000, 17, 35–49. [Google Scholar] [CrossRef]
- Kobayashi, Y.; Kobayashi, A.; Hagiwara, K.; Uga, H.; Mikoshiba, Y.; Naito, T.; Honda, Y.; Omura, T. Gentian mosaic virus: A new species in the genus Fabavirus. Phytopathology 2005, 95, 192–197. [Google Scholar] [CrossRef] [PubMed]
- Zhang, G.; Wang, C.; Ren, X.; Li, Z.; Liu, C.; Qiao, X.; Shen, S.; Zhang, F.; Wan, F.; Liu, B. Inhibition of invasive plant Mikania micrantha rapid growth by host-specific rust (Puccinia spegazzinii). Plant Physiol. 2023, 192, 1204–1220. [Google Scholar] [CrossRef] [PubMed]
- Tan, M.; Zhang, Y.; Zhang, Y.; Vurro, M.; Qiang, S. Effects of Bipolaris yamadae strain HXDC-1-2 as a bioherbicide against Echinochloa crus-galli in rice and dry fields. Pest Manag. Sci. 2024, 80, 3786–3794. [Google Scholar] [CrossRef] [PubMed]
- Barrios-González, J.; Tarragó-Castellanos, M.R. Solid-State Fermentation: Special Physiology of Fungi. In Fungal metabolites; Reference Series in Phytochemistry; Springer: Cham, Switzerland, 2017; pp. 319–347. [Google Scholar]
- Tomley, A.; Evans, H. Establishment of, and preliminary impact studies on, the rust, Maravalia cryptostegiae, of the invasive alien weed, Cryptostegia grandiflora in Queensland, Australia. Plant Pathol. 2004, 53, 475–484. [Google Scholar] [CrossRef]
- Kremer, R.J. The role of bioherbicides in weed management. Biopestic. Int. 2005, 1, 4. [Google Scholar]
- Green, J.M. Current state of herbicides in herbicide-resistant crops. Pest Manag. Sci. 2014, 70, 1351–1357. [Google Scholar] [CrossRef]
- Ye, F.; Feng, L. Progress of research and application on microbial herbicides. J. Northeast Agric. Univ. 2010, 41, 139–143. [Google Scholar]
- Tsuge, T.; Harimoto, Y.; Akimitsu, K.; Ohtani, K.; Kodama, M.; Akagi, Y.; Egusa, M.; Yamamoto, M.; Otani, H. Host-selective toxins produced by the plant pathogenic fungus Alternaria alternata. FEMS Microbiol. Rev. 2013, 37, 44–66. [Google Scholar] [CrossRef]
- Wang, C.; Li, C.; Li, B.; Li, G.; Dong, X.; Wang, G.; Zhang, Q. Toxins produced by Valsa mali var. mali and their relationship with pathogenicity. Toxins 2014, 6, 1139–1154. [Google Scholar] [CrossRef]
- Daniel, J.; Templeton, G.; Smith, R.; Fox, W. Biological control of northern jointvetch in rice by an endemic fungal disease. Weed Sci. 1973, 21, 303–307. [Google Scholar] [CrossRef]
- Greaves, M.P.; Bailey, J.A.; Hargreaves, J.A. Mycoherbicides: Opportunities for genetic manipulation. Pestic. Sci. 1989, 26, 93–101. [Google Scholar] [CrossRef]
- Hongzhong, F.; Guangyu, S. Advances in the classification of Alternaria and related genera. J. Fungal Res. 2020, 18, 294–303. [Google Scholar]
- Somma, S.; Amatulli, M.T.; Masiello, M.; Moretti, A.; Logrieco, A.F. Alternaria species associated to wheat black point identified through a multilocus sequence approach. Int. J. Food Microbiol. 2019, 293, 34–43. [Google Scholar] [CrossRef] [PubMed]
- Jiang, D.; Wei, D.; Li, H.; Wang, L.; Jiang, N.; Li, Y.; Wang, M. Natural occurrence of Alternaria mycotoxins in wheat and potential of reducing associated risks using magnolol. J. Sci. Food Agric. 2021, 101, 3071–3077. [Google Scholar] [CrossRef] [PubMed]
- Bathoova, M.; Švubová, R.; Bokor, B.; Neděla, V.; Tihlaříková, E.; Martinka, M. Silicon triggers sorghum root enzyme activities and inhibits the root cell colonization by Alternaria alternata. Planta 2021, 253, 29. [Google Scholar] [CrossRef]
- Zhang, D.; He, J.-Y.; Haddadi, P.; Zhu, J.-H.; Yang, Z.-H.; Ma, L. Genome sequence of the potato pathogenic fungus Alternaria solani HWC-168 reveals clues for its conidiation and virulence. BMC Microbiol. 2018, 18, 176. [Google Scholar] [CrossRef]
- Mohamad, O.A.; Li, L.; Ma, J.-B.; Hatab, S.; Xu, L.; Guo, J.-W.; Rasulov, B.A.; Liu, Y.-H.; Hedlund, B.P.; Li, W.-J. Evaluation of the antimicrobial activity of endophytic bacterial populations from Chinese traditional medicinal plant licorice and characterization of the bioactive secondary metabolites produced by Bacillus atrophaeus against Verticillium dahliae. Front. Microbiol. 2018, 9, 924. [Google Scholar] [CrossRef]
- Abdessemed, N.; Staropoli, A.; Zermane, N.; Vinale, F. Metabolic profile and mycoherbicidal activity of three Alternaria alternata isolates for the control of Convolvulus arvensis, Sonchus oleraceus, and Xanthium strumarium. Pathogens 2021, 10, 1448. [Google Scholar] [CrossRef]
- Saxena, S.; Kumar, M. Evaluation of Alternaria alternata ITCC4896 for use as mycoherbicide to control Parthenium hysterophorus. Arch. Phytopathol. Plant Prot. 2010, 43, 1160–1164. [Google Scholar] [CrossRef]
- Kang, Y.; Feng, H.; Zhang, J.; Chen, S.; Valverde, B.E.; Qiang, S. TeA is a key virulence factor for Alternaria alternata (Fr.) Keissler infection of its host. Plant Physiol. Biochem. 2017, 115, 73–82. [Google Scholar] [CrossRef]
- Yang, M.; He, Z.; Huang, Y.; Lu, L.; Yan, Y.; Hong, L.; Shen, H.; Liu, Y.; Guo, Q.; Jiang, L. The emergence of the hyperinvasive vine, Mikania micrantha (Asteraceae), via admixture and founder events inferred from population transcriptomics. Mol. Ecol. 2017, 26, 3405–3423. [Google Scholar] [CrossRef] [PubMed]
- Choudhury, M.R.; Deb, P.; Singha, H.; Chakdar, B.; Medhi, M. Predicting the probable distribution and threat of invasive Mimosa diplotricha Suavalle and Mikania micrantha Kunth in a protected tropical grassland. Ecol. Eng. 2016, 97, 23–31. [Google Scholar] [CrossRef]
- Deori, C.; Dutta, G.; Das, S.; Phukan, D. Analgesic activity of ethanolic extract of leaves of Mikania micrantha on experimental animal models. Pharma Sci. Monit. 2016, 7, 168–173. [Google Scholar]
- Li, P.-l.; Liu, M.-h.; Hu, J.-h.; Su, W.-w. Systematic chemical profiling of Citrus grandis ‘Tomentosa’by ultra-fast liquid chromatography/diode-array detector/quadrupole time-of-flight tandem mass spectrometry. J. Pharm. Biomed. Anal. 2014, 90, 167–179. [Google Scholar] [CrossRef] [PubMed]
- Sammons, R.D.; Gaines, T.A. Glyphosate resistance: State of knowledge. Pest Manag. Sci. 2014, 70, 1367–1377. [Google Scholar] [CrossRef] [PubMed]
- Luo, C.; Chen, Y.; Guo, R.; Fang, W.; Wu, X.; Wang, B. First Report of Alternaria gossypina Causing Stem Base Rot on Passilora edulis in Guangxi, China. Plant Dis. 2024. [Google Scholar] [CrossRef]
- Gou, Y.; Aung, S.L.L.; Guo, Z.; Li, Z.; Shen, S.; Deng, J. Four New Species of Small-Spored Alternaria Isolated from Solanum tuberosum and S. lycopersicum in China. J. Fungi 2023, 9, 880. [Google Scholar] [CrossRef]
- Guo, Z.-J.; Cai, L.-T.; Huang, C.-X.; Gou, Y.-N.; Deng, J.-X.; Wang, H.-C. First Report of Tobacco Leaf Tip Blight Caused by Alternaria gossypina in China. Plant Dis. 2024, 108, 1887. [Google Scholar] [CrossRef]
- Li, E.; Liu, J.; Zhang, S.; Xu, B. Identification the Pathogen Cause a New Apple Leaf Blight in China and Determination the Controlling Efficacy for Five Botanical Fungicides. J. Fungi 2024, 10, 255. [Google Scholar] [CrossRef]
- Woudenberg, J.; Seidl, M.; Groenewald, J.; De Vries, M.; Stielow, J.; Thomma, B.; Crous, P. Alternaria section Alternaria: Species, formae speciales or pathotypes? Stud. Mycol. 2015, 82, 1–21. [Google Scholar] [CrossRef]
- Chen, S.; Zhou, E.; Dong, F.; Hong, W.; Wei, Y.; Zhang, J.; Niu, Q.; Tian, F. First Report of Alternaria alternata Causing Leaf Spot on Catalpa bungei in China. Plant Dis. 2024, PDIS-01-24-0091-PDN. [Google Scholar] [CrossRef] [PubMed]
- Kaspary, T.; García, M.; Stewart, S.; Casaroto, G.; Ramos, R.; Bellé, C. First report of Alternaria alternata causing leaf spot on Rumex crispus in Uruguay. Plant Dis. 2019, 103, 21–39. [Google Scholar] [CrossRef]
- Motlagh, M.R.S. Evaluation of Alternaria alternata causing leaf spot of barnyardgrass grown in rice fields. Afr. J. Microbiol. Res. 2012, 6, 4481–4488. [Google Scholar]
- Bozoğlu, T.; Alkan, M.; Derviş, S.; Özer, G. Leaf spot caused by Alternaria crassa on Datura stramonium in Turkey. Australas. Plant Dis. Notes 2022, 17, 26. [Google Scholar] [CrossRef]
- Li, Y.-X.; Dong, X.-F.; Yang, A.-L.; Zhang, H.-B. Diversity and pathogenicity of Alternaria species associated with the invasive plant Ageratina adenophora and local plants. PeerJ 2022, 10, e13012. [Google Scholar] [CrossRef]
- Li, Y.; Sun, Z.; Zhuang, X.; Xu, L.; Chen, S.; Li, M. Research progress on microbial herbicides. Crop Prot. 2003, 22, 247–252. [Google Scholar] [CrossRef]
- Tao, D.; Anyang, F.; Guaglin, C.; Longyun, L.; Xuhong, S. Identification of the pathogen causing leaf brown spot on Citrus medica var. sarcodactylis and screening of fungicides for the control of the disease. Acta Phytopathol. Sin. 2023, 53, 769–778. [Google Scholar]
- Prendes, L.P.; Zachetti, V.G.L.; Pereyra, A.; Morata de Ambrosini, V.; Ramirez, M.L. Water activity and temperature effects on growth and mycotoxin production by Alternaria alternata strains isolated from Malbec wine grapes. J. Appl. Microbiol. 2017, 122, 481–492. [Google Scholar] [CrossRef]
- Chandrasekaran, M.; Sathiyabama, M. Production, partial purification and characterization of protease from a phytopathogenic fungi Alternaria solani (E ll. and Mart.) Sorauer. J. Basic Microbiol. 2014, 54, 763–774. [Google Scholar] [CrossRef]
- Blagojević, J.; Vukojević, J.; Ivanović, B.; Ivanović, Ž. Characterization of Alternaria species associated with leaf spot disease of Armoracia rusticana in Serbia. Plant Dis. 2020, 104, 1378–1389. [Google Scholar] [CrossRef]
- Gudesblat, G.E.; Torres, P.S.; Vojno, A.A. Stomata and pathogens: Warfare at the gates. Plant Signal. Behav. 2009, 4, 1114–1116. [Google Scholar] [CrossRef] [PubMed]
- Mengiste, T. Plant immunity to necrotrophs. Annu. Rev. Phytopathol. 2012, 50, 267–294. [Google Scholar] [CrossRef] [PubMed]

| Class | Rank/Numerical Value | % of Infected Leaf Area |
|---|---|---|
| I | 0 | Disease free |
| II | 1 | 1–10 |
| III | 2 | 11–25 |
| IV | 3 | 26–50 |
| V | 4 | 51–75 |
| VI | 5 | >76 |
| Gene/Sequence | Primer | Primer Sequence (5′→3′) |
|---|---|---|
| ITS | ITS1 | TCCGTAGGTGAACCTGCGG |
| ITS4 | TCCTCCGCTTATTGATATGC | |
| gpd | gpd1 | CAACGGCTTCGGTCGCATTG |
| gpd2 | GCCAAGGAGTTGGTTGTGC | |
| Alta-1 | Alt-for | ATGCAGTTCACCACCATCGC |
| Alt-rev | ACGAGGGTGAYGTAGGCGTC |
Disclaimer/Publisher’s Note: The statements, opinions and data contained in all publications are solely those of the individual author(s) and contributor(s) and not of MDPI and/or the editor(s). MDPI and/or the editor(s) disclaim responsibility for any injury to people or property resulting from any ideas, methods, instructions or products referred to in the content. |
© 2024 by the authors. Licensee MDPI, Basel, Switzerland. This article is an open access article distributed under the terms and conditions of the Creative Commons Attribution (CC BY) license (https://creativecommons.org/licenses/by/4.0/).
Share and Cite
Feng, L.; Hu, L.; Bo, J.; Ji, M.; Ze, S.; Ding, Y.; Yang, B.; Zhao, N. Identification and Biological Characteristics of Alternaria gossypina as a Promising Biocontrol Agent for the Control of Mikania micrantha. J. Fungi 2024, 10, 691. https://doi.org/10.3390/jof10100691
Feng L, Hu L, Bo J, Ji M, Ze S, Ding Y, Yang B, Zhao N. Identification and Biological Characteristics of Alternaria gossypina as a Promising Biocontrol Agent for the Control of Mikania micrantha. Journal of Fungi. 2024; 10(10):691. https://doi.org/10.3390/jof10100691
Chicago/Turabian StyleFeng, Lichen, Lianrong Hu, Jingyi Bo, Mei Ji, Sangzi Ze, Yan’e Ding, Bin Yang, and Ning Zhao. 2024. "Identification and Biological Characteristics of Alternaria gossypina as a Promising Biocontrol Agent for the Control of Mikania micrantha" Journal of Fungi 10, no. 10: 691. https://doi.org/10.3390/jof10100691
APA StyleFeng, L., Hu, L., Bo, J., Ji, M., Ze, S., Ding, Y., Yang, B., & Zhao, N. (2024). Identification and Biological Characteristics of Alternaria gossypina as a Promising Biocontrol Agent for the Control of Mikania micrantha. Journal of Fungi, 10(10), 691. https://doi.org/10.3390/jof10100691

